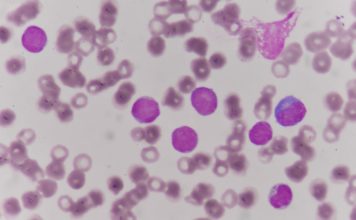

Ученые извлекают белковые наномашины из бактерий
Сегодня талантливая команда микробиологов из Университета Южной Калифорнии в США представили результаты своей достаточн...
Создан первый эндоскелет для мужского органа
Проблема отсутствия эрекции у мужчин становится все более масштабной и многие ученые подключились к решению такого интим...
Плохое настроение лучше сказывается на продуктивности, чем хорошее
Очередное необычное исследование показало, что недовольство человека может позитивно сказаться на его продуктивности, та...
Техасское побережье признано одним из грязнейших среди стран Персидского залива
Забота об экологии становится просто невозможной без правильного предварительного анализа той или иной ситуации – как э...
Ученые в Торонто отключали гены чтобы найти самые нужные
Команда исследователей из Университета Торонто изучала человеческий геном, последовательно отключая гены в попытке намет...
Потеря генов может быть полезной в долгосрочной перспективе
На протяжении процесса эволюции живых организмов гены и генные сочетания непрестанно меняются, развиваются и некоторые ...
Проведено новое сравнительное исследование между табаком и вейпингом
Курение – весьма опасная и вредная привычка, которая становится одним из основных факторов развития различных сердечно...
Обнаружены бактерии способные выжить на Марсе
Если ученым удастся найти на Марсе микробы, это будет открытие века, и, конечно, любое уважающее себя космическое агентс...
Найден уникальный способ устранить апноэ во сне
Не секрет, что так называемый синдром апноэ во сне – когда верхние дыхательные пути человека временно блокируются из-за...
Американский ученый обещает воскрешать мертвых
Медицинский прогресс означает, что в скором времени будет возможно вернуть мертвого к жизни, как утверждает доктор Сэм П...